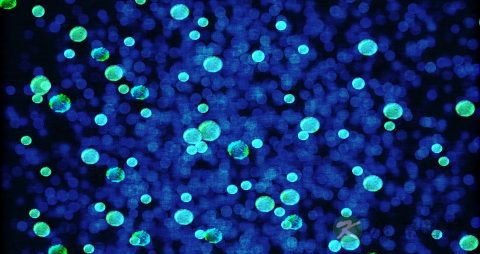

1、多肽是什么
多肽是α-氨基酸以肽键连接在一起而形成的化合物,它也是蛋白质水解的中间产物。由两个氨基酸分子脱水缩合而成的化合物叫做二肽,同理类推还有三肽、四肽、五肽等。通常由三个或三个以上氨基酸分子脱水缩合而成的化合物都可以成为叫多肽。 在高二选修有机化学基础中有对多肽的明确定义。
2、多肽应该如何保存
多肽类保健食品只需置于阴凉干燥处即可。
对于多肽试剂和多肽类药物则需要保存在干燥器中。在将它们暴露于空气之前, 冷冻干燥多肽可以放于室温。这将是湿度影响减少,当无法冷冻干燥时,最好的方法是以小的工作样量存放。对于含Cys, Met orTrP的多肽试剂,脱氧缓冲剂对其溶解必不可少,因为这种多肽试剂易被空气氧化,在封瓶前,慢慢流过多肽试剂的氮气或氩气也会降低氧化作用。含Gln或Asn的多肽试剂也容易降解,所有这些肽与不含这些有问题解苷的那些肽相比,生命期有限。
3、活性多肽又是什么
活性多肽(HGH)它是一种由人体自身分泌的一种物质,又叫人类生长素(HGH),HGH是由191个氨基酸组成,由脑下垂体分泌,主要分布在神经组织和其他组织器官中。参与了人体的生长发育和蛋白质、脂肪、糖三大物质的代谢,正是因为它在体内分泌量的增多或减少,控制着蛋白质的正常合成速度,质量,控制着细胞的正常复制和合成。常见作为细胞内部或细胞间传输化学信号的信使,调控细胞间或器官间的行动。包括神经、免疫、衰老等许多最新的研究方向都与小小的活性肽有关。常见而重要的活性多肽包括:谷胱甘肽GSH、催产素、脑肽等等。

液相合成:基于将单个N-α保护氨基酸反复加到生长的氨基成份上,合成一步步地进行, 通常从合成链的C端氨基酸开始,接着的单个氨基酸的连接通过用DCC,混合炭酐, 或N-carboxy酐方法实现。Carbodiimide方法包括用DCC做连接剂连接N-和C-保护氨基酸。
重要的是, 这种连接试剂促接N保护氨基酸自己炭基和C保护氨基酸自由氨基间的缩水,形成肽链, 同时产出N,N?/FONT>-dyaylcohercylurea副产物。然而, 此方法因其导致消旋的副反应,或在强碱存在时形成5(4H)-oxaylones和N-acylurea而受到影响。庆幸地是, 这些副反应能最小化,但是还不能完全消除。方法是加入象HoSu或HoBT这样的连接催化剂, 此外,此方法也可用于合成N保护氨基酸的活性酯衍生物。依次产生的活性酯将自发与任何别的C保护氨基酸或肽反应形成新的肽。
1、提供多种氨基酸,多肽帮助身体制造新的组织替代坏死的组织。
2、提供构造新组织所需的氨基酸。
3、通过鉴定血液向细胞输送氧和各种营养物质。

4、调节体内的水分,电解质平衡。
5、为免疫系统制造对抗细菌和感染的抗体,提高免疫功能。
6、帮助伤口血液凝固促进伤口愈合。
7、在体内制造酵素,有助于将食物转化为能量。
8、修复细胞,改善细胞代谢,防止细胞变性,能起到防癌,抗癌的作用。
9、促进蛋白质,酶,酵素的调控。
10、沟通细胞间,器官间信息的重要化学信史。
11、消除心脑血管疾病。
12、改善内分泌与神经系统。
13、改善消化系统,改善慢性肠道疾病。
14、对风湿,类风湿,糖尿病,等疾病效果显着。
15、抗病毒感染,抗衰老,消除体内多余的自由基。
16、促进造血功能,改善贫血,防止血小板凝集,能提高血红细胞的载氧能力。
豫公网安备 41110202000246号互联网药品信息服务资格证书:(豫)-经营性-2022-0039增值电信业务经营许可证:豫B2-20221313医疗器械经营备案编号:豫郑食药监械经营备20212188号



